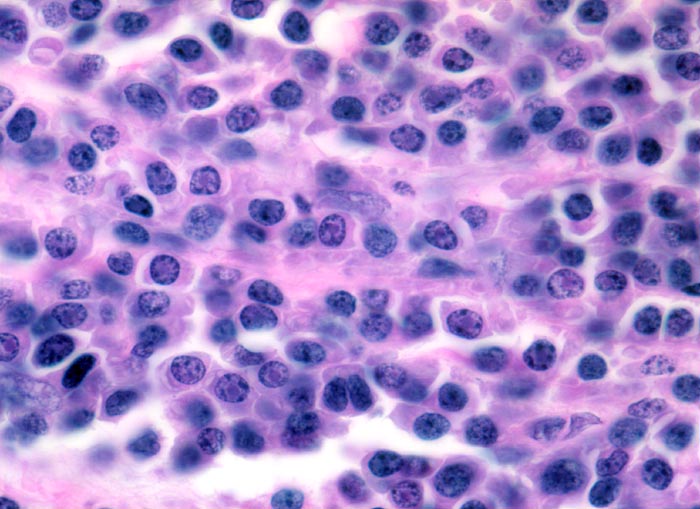

PathoPic – image database / PathoPic ID 4164 - Multiples Myelom: Dutcher bodies
de
Diagnose
Multiples Myelom: Dutcher bodies
Diagnose Gruppe
maligner Tumor
Topographie
Knochenmark, Wirbelkörper
Topographie Gruppe
Lymphatische Gewebe, KM, Milz
Beschreibung
Klinik
Notfalleinweisung wegen umschriebenen Thoraxschmerzen ohne adäquates Trauma. Im Röntgenbild Nachweis multipler Frakturen der Wirbelsäule und der Rippen bei grobsträhniger Osteoporose. In der Serumelektrophorese Nachweis einer Paraproteinämie.
Kommentar
Bei den Dutcher bodies handelt es sich nicht um echte Kerneinschlüsse, sondern um Zytoplasmaeinstülpungen in den Kern. Diese Einstülpungen enthalten Immunglobuline. Dutcher bodies treten auf bei monoklonaler Immunglobulinproduktion. Sie sind nicht spezifisch für multiple Myelome, sondern können auch beim Morbus Waldenström, lymphoplasmozytischen Lymphomen oder MALT Lymphomen auftreten.
Bilder Typ
Histologie
Vergrösserung
630
Alter
64
Geschlecht
männlich
Datum
Ersteintrag: 04.03.2002